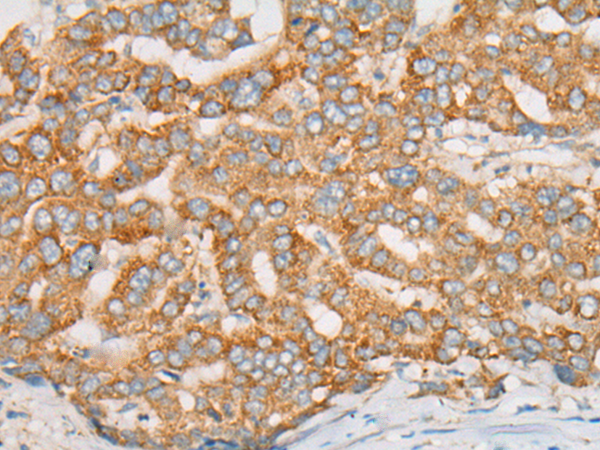

中文名稱:兔抗ATXN7多克隆抗體
|
Background: |
The autosomal dominant cerebellar ataxias (ADCA) are a heterogeneous group of neurodegenerative disorders characterized by progressive degeneration of the cerebellum, brain stem and spinal cord. Clinically, ADCA has been divided into three groups: ADCA types I-III. ADCAI is genetically heterogeneous, with five genetic loci, designated spinocerebellar ataxia (SCA) 1, 2, 3, 4 and 6, being assigned to five different chromosomes. ADCAII, which always presents with retinal degeneration (SCA7), and ADCAIII often referred to as the 'pure' cerebellar syndrome (SCA5), are most likely homogeneous disorders. Several SCA genes have been cloned and shown to contain CAG repeats in their coding regions. ADCA is caused by the expansion of the CAG repeats, producing an elongated polyglutamine tract in the corresponding protein. The expanded repeats are variable in size and unstable, usually increasing in size when transmitted to successive generations. This locus has been mapped to chromosome 3, and it has been determined that the diseased allele associated with spinocerebellar ataxia-7 contains 38-130 CAG repeats (near the N-terminus), compared to 7-17 in the normal allele. The encoded protein is a component of the SPT3/TAF9/GCN5 acetyltransferase (STAGA) and TBP-free TAF-containing (TFTC) chromatin remodeling complexes, and it thus plays a role in transcriptional regulation. Alternative splicing results in multiple transcript variants. |
|
Applications: |
ELISA, IHC |
|
Name of antibody: |
ATXN7 |
|
Immunogen: |
Synthetic peptide of human ATXN7 |
|
Full name: |
ataxin 7 |
|
Synonyms: |
SCA7; OPCA3; ADCAII |
|
SwissProt: |
O15265 |
|
ELISA Recommended dilution: |
5000-10000 |
|
IHC positive control: |
Human liver cancer and human lung cancer |
|
IHC Recommend dilution: |
50-300 |

購物車
幫助
021-54845833/15800441009
